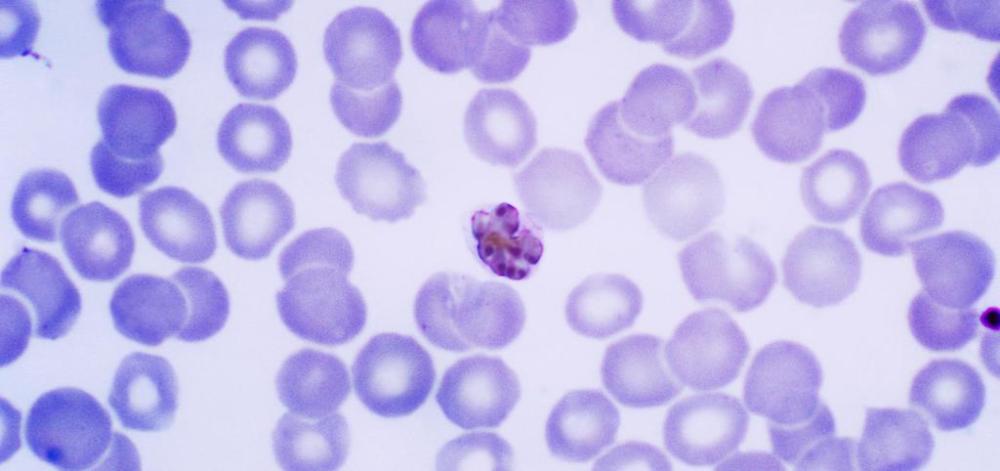

Esdeveniments
Busca eventos
Esdeveniments passats


Malaria: Investigación con impacto en tiempos de COVID-19
Ponent Varios ponentes Recerca, Eliminació de la malària
MESA Webinar 6 - Malaria in the Shadows: Putting the Focus on the Challenges of P. vivax
Ponents Marcus Lacerda (Tropical Medicine Foundation Dr Heitor Vieira Dourado, FMT-HVD, Brazil) and Wanlapa Roobsoong (Mahidol University, Thailand) Recerca, Eliminació de la malària
MESA Webinar 5 - Below the Target: Innovative Ways to Accelerate Increase in IPTp Coverage
Ponents Ogonna Nwankwo ( University of Calabar, Nigeria) and Jenipher Mukolwe Angaha (Jhpiego, Kenya) Recerca, Eliminació de la malària
Immunització, com funciona?
Ponent Carlota Dobaño (ISGlobal) Recerca, Eliminació de la malària
Basic and Applied Research Approaches Focusing on 'Plasmodium falciparum' Gametocytes
Ponents Till Voss (Swiss Tropical & Public Health Institute) Recerca, Eliminació de la malària
La màlaria en el punt de mira
Ponents Antoni Trilla, Antoni Plasència, Quique Bassat Eliminació de la malària
Functional Profiling of a 'Plasmodium' Genome
Ponent Prof. Oliver Billker (Wellcome Sanger Institute) Recerca, Eliminació de la malària
115 Years of Malaria in Africa: A Brief History and Future Outlook
Ponent Bob Snow (KEMRI-Wellcome Trust Programme) Recerca, Eliminació de la malària
The 'P. falciparum' Dry Season Reservoir: A Long Game of Hide and Seek
Ponent Silvia Portugal (Universitäts Klinikum Heidelberg) Eliminació de la malària
Malaria Pathogenesis: Anemia and Cerebral Malaria
Ponent Ana Rodríguez (NYU) Recerca, Eliminació de la malària
Modelling Optimal Packages of Interventions Towards Malaria Elimination
Ponents Patrick Walker (Imperial College, London) Recerca, Eliminació de la malària
Malaria Parasite Population Genetics and Adaptation to Diverse Environments
Ponent David Conway (LSHTM) Recerca, Eliminació de la malària
Strengthening Health Systems in Liberia after the 2014-16 Ebola Epidemics: Building a Critical Mass for Malaria Research
Ponents Alfredo Mayor & Guillermo Martínez (ISGlobal) Recerca, Eliminació de la malària
A Broad View of Ivermectin for Malaria from Cattle to Policy
Ponents Carlos Chaccour & Regina Rabinovich (ISGlobal) Recerca, Eliminació de la malària
Malaria Parasites in the Mosquito: Exploring New Targets for Intervention
Ponent Inga Siden-Kiamos (IMBB-FORTH) Recerca, Eliminació de la malària
Evolutionary Loss of alpha 1,3-galactosyltransferases Enhanced Resistance to Pathogens
Ponent Miguel Soares (Instituto Gulbelkian de Ciência) Recerca, Eliminació de la malària
Paratransgenic Approaches to Vector-Borne Disease
Ponents Ravi Durvasula (University of New Mexico, USA) Recerca, Eliminació de la malària
The Past, Present and Threatened Future of Residual Malaria Transmission
Ponents Gerry Killeen (LSTM & Ifakara Health Institute) Recerca, Eliminació de la malària
Extracellular Vesicles in the Regulation of Host-Pathogen Interactions During Malaria
Ponent Pierre-Yves Mantel (University of Fribourg) Recerca, Eliminació de la malària
Revisiting the Biology of Malaria Transmission in an Era of Elimination
Ponent Matthias Marti Recerca, Eliminació de la malària
Facebook Live con Matiana González Silva: Día Mundial de la Malaria
Ponent Matiana González Silva (ISGlobal) Recerca, Translació i Impacte, Eliminació de la malària
Evaluation of a Community Approach of Malaria Preventive Strategies in Pregnancy
Ponent Raquel González (ISGlobal) Recerca, Eliminació de la malària
Development of Enabling Technologies for Understanding Malaria Transmission Biology at Micro- and Macro-Scales
Ponent Rhoel Dinglasan Recerca, Eliminació de la malària
Bringing Innovation to the Front Line: New Tools to Advance the Global Response to Vector-Borne Diseases
Recerca, Translació i Impacte, Eliminació de la malària
Plasmodium vivax and Exosomes: Is There a Link?
Ponent Hernando del Portillo (ICREA Research Professor at ISGlobal) Recerca, Eliminació de la malària
Plasmodium: Die Another Day (Five Years of the Nanomalaria Group at ISGlobal)
Ponent Xavier Fernández (ISGlobal) Recerca, Eliminació de la malària
Making the Most Out of Our Toolbox – IPTp in the Context of Antimalarial Resistance and HIV Co-Infections
Ponent Silvie Huijben (ISGlobal) Recerca, Eliminació de la malària
Expression Patterns of Plasmodium Falciparum Clag3 Genes in Human Infections
Ponent Sofia Mira (ISGlobal) Recerca, Eliminació de la malària